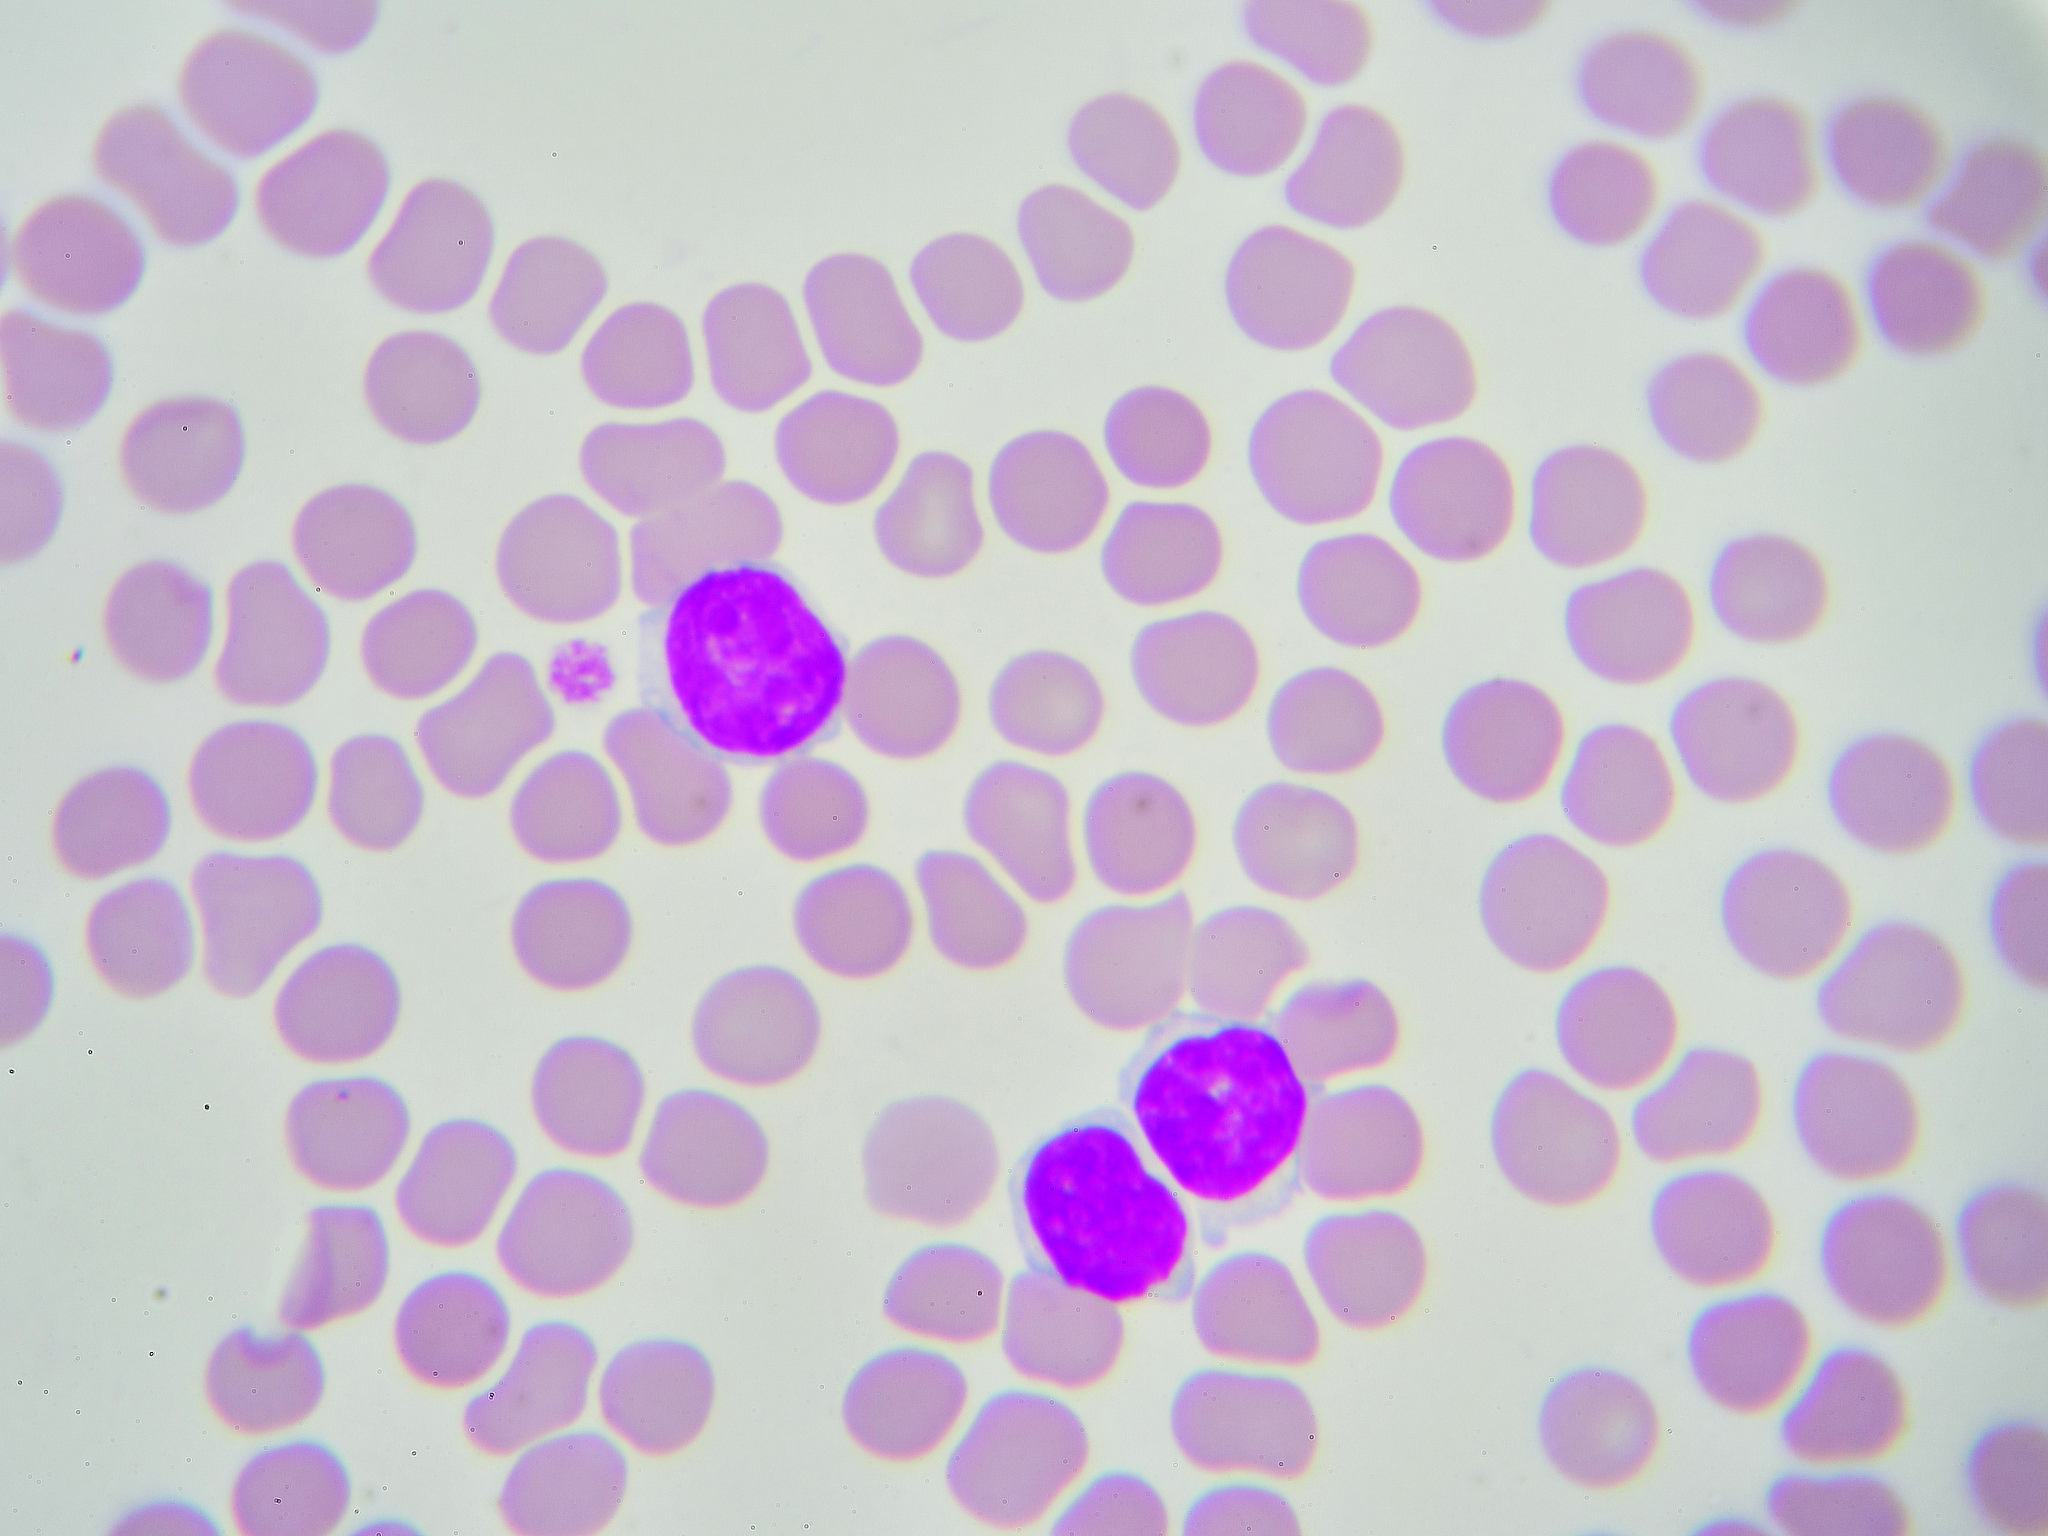
急性红细胞白血病诊断标准 - 罕见白血病亚型

急性红细胞白血病诊断标准 - 罕见白血病亚型
急性红细胞白血病(Acute erythroid leukemia,AEL)是一种罕见的急性白血病亚型,通常表现为严重的贫血、出血和感染症状。目前,AEL的诊断标准如下:
-
骨髓中原始和成熟的红系细胞增生,并存在至少20%的原始红系细胞(包括原始红细胞、幼稚红细胞和巨幼红细胞)。
-
骨髓中存在白血病细胞,其数量可以是20%或更少。
-
骨髓中存在其他成熟或未成熟的造血细胞,如粒系细胞、单核细胞、巨核细胞等,但它们的数量通常比红系细胞少。
-
在外周血或骨髓中,至少存在一种红系细胞的衍生物,如网织红细胞、原始红细胞、幼稚红细胞或巨幼红细胞。
-
骨髓中存在的红系细胞呈现异常形态或功能,如核分裂、不成熟、异型性等。
-
骨髓中存在的白血病细胞呈现红系细胞的特征,如原始红细胞、幼稚红细胞、巨幼红细胞等,并具有白血病细胞的特征,如异型性、核分裂、染色体异常等。
最终的AEL诊断需要综合以上标准,并排除其他造血细胞异常增生和白血病亚型,如急性髓样白血病、急性单核细胞白血病等。
原文地址: https://www.cveoy.top/t/topic/lNyH 著作权归作者所有。请勿转载和采集!